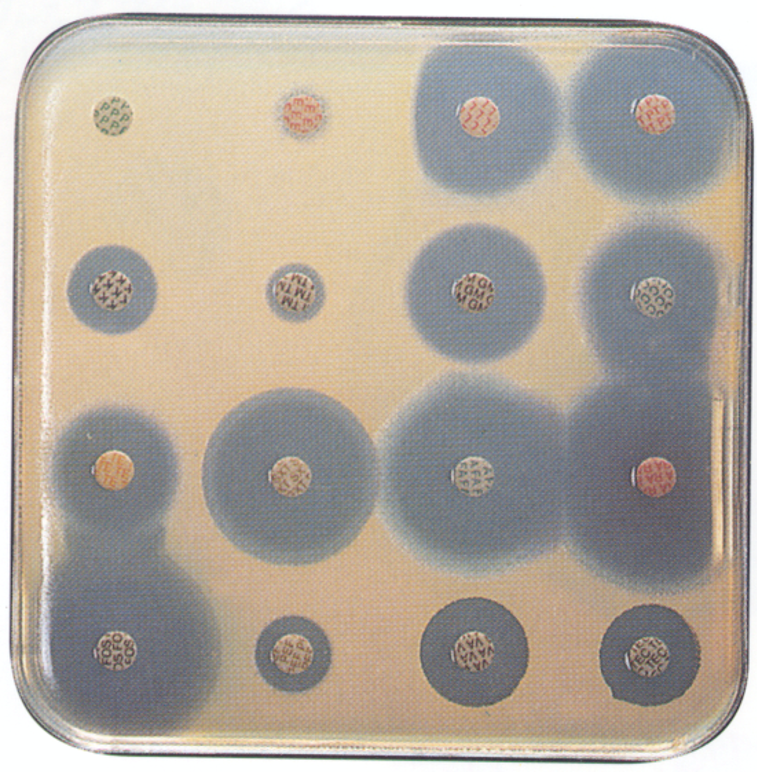

Participez à la formation
sur les bases et la lecture interprétative
de l’antibiogramme
Familiarisez vous avec les dernières recommandations du CA-SFM pour une meilleure réalisation et lecture des antibiogrammes pour les différentes espèces pathogènes.
Echangez avec des experts hospitaliers sur vos cas pratiques pour enrichir vos connaissances et améliorez la pertinence de vos échanges avec les cliniciens au profit de vos patients.
Formation biologiste
Inscrivez-vous
OBJECTIFS de la formation
Mieux interpréter l'antibiogramme
01
Savoir
Se familiariser avec la nouvelle version du document du CA-SFM
02
Savoir-faire
Savoir interpréter les résultats d'antibiogrammes avant de les transmettre aux cliniciens
03
Savoir-être
Expérimenter par des mises en situation et anticiper les questions des cliniciens
CONTENU de la formation
- 1ère demi-journée : notions de base sur la réalisation de l’antibiogramme et son interprétation.
- 2ème demi-journée : ateliers interactifs sur les antibiogrammes « courants » et sur ceux « en l’absence de concentration critique clinique ».
Évaluations et Suivi
Nombre de participants
Intervenants experts
Tarif
500 € HT Module de base 2025
620 € HT Module expert 2025
Modalités techniques
Méthodes et moyens pédagogiques :
- Méthode affirmative : Apports théoriques avec lecture et compréhension du dernier document du CA-SFM – Questionnaire d’évaluation Avant/Après
- Méthode interrogative : Echanges interactifs avec ateliers d'interprétation des résultats et partage d’expérience